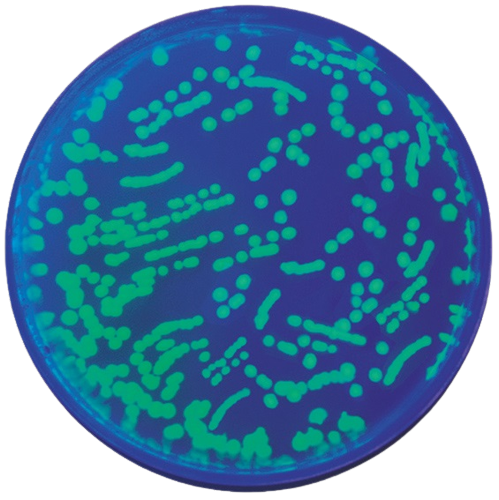
Kit transformation d'Escherichia coli avec la GFP

Kit transformation d'Escherichia coli avec la GFP
Ce produit n'est plus disponible.
Les cellules transformées ont un plasmide contenant le gène de la GFP pour Green Fluorescent Protein isolé à partir de la méduse Aequorea victoria. Les colonies transformées exprimant la protéine GFP sont visiblement vertes à la lumière normale, mais d’une fluorescence vive lorsqu’elles sont exposées à la lumière UV.
Comprend : instructions, BactoBeads GFP hôte Escherichia coli, pFluoroGreen (plasmide), l’ampicilline, IPTG, CaCl2, agar Luria, milieu Luria (stérile) de bouillon pour la relance (stérile), des boîtes de Pétri (petites et grandes), pipettes de transfert enveloppées, 10mL pipette (stérile), des cure-dents (stériles), des tubes à centrifuger (stériles).
Pour 10 groupes de laboratoire